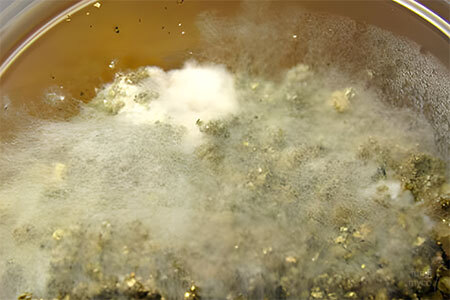
Dactylium - mushroom contaminant

10 Most Common Mushroom Contaminations (Ultimate Identification & Prevention Guide)
What is mushroom contamination and how can I prevent it? — Quick Answer
Mushroom contamination is the single biggest reason beginner grows fail — and most of it is preventable once you know what you're looking at. Green, black, pink, orange and yellow patches all mean different things, and responding correctly depends on identifying the contaminant accurately. Trichoderma is the most common offender; wet rot and bacterial blotch are the most frequently misdiagnosed. This article covers all ten contaminants you're realistically likely to encounter, with a visual identification section that shows exactly what healthy mycelium looks like versus the warning signs. I've lost more grows than I'd like to admit before I understood this properly. Get the identification right first — prevention becomes significantly easier once you can see what you're fighting.
What is mushroom contamination?

Mushroom contamination occurs when unwanted organisms — such as mould, bacteria, or yeast contamination — invade your grow and compete with mushroom mycelium.
Why Contamination Happens
The Biology Behind It (Why Contaminants Win)
Contaminants like Trichoderma and bacteria reproduce faster than mushroom mycelium. They:
This is why early detection is critical.
Healthy vs Contaminated Mycelium (Visual Identification Guide)

Healthy Mycelium Characteristics
Contaminated Mycelium Signs
Quick Identification Table
|
Contaminant |
Colour |
Texture |
Growth Speed |
Smell |
Common Stage |
|---|---|---|---|---|---|
|
Green |
Powdery |
Fast |
Musty |
Grain/Bulk |
|
|
Grey |
Wispy |
Very Fast |
Mild |
Fruiting |
|
|
Yellow/Brown |
Slimy |
Medium |
Sour |
Grain |
|
|
Black |
Dusty |
Medium |
Musty |
Any |
|
|
Blue-Green |
Powdery |
Fast |
Musty |
Any |
|
|
Red/Orange |
Patchy |
Fast |
Neutral |
Grain |
|
|
Cream |
Smooth |
Medium |
Fermented |
Agar/Grain |
|
|
Pink |
Fuzzy |
Fast |
Mild |
Bulk |
|
|
Orange |
Wet blobs |
Medium |
Sweet/Rotten |
Fruiting |
|
|
White with black tips |
Tall, fuzzy with pinheads |
Fast |
Mild to musty |
Agar / Grain spawn |
The 10 Most Common Mushroom Contaminations
1. Trichoderma (Green Mould Contamination)

Identification:
Common In:
Why It Happens:
Prevention:
Expert Tip:
In real grows, Trichoderma often appears right before full colonisation, when growers become less cautious.
2. Cobweb Mould (Dactylium Contamination)
Identification:
Common In:
Why It Happens:
Prevention:
Expert Tip:
Early treatment with hydrogen peroxide can stop it.
3. Wet Spot / Sour Rot (Bacillus/Bacterial Contamination)

Identification:
Common In:
Why It Happens:
Prevention:
Expert Tip:
If you’re unsure whether a jar is bacterial, give it a shake — healthy mycelium will recover quickly, but Bacillus-contaminated grain will stall or appear greasy and clumped.
4. Black Mould (Aspergillus Contamination)

Identification:
Common In:
Why It Happens:
Prevention:
Expert Tip:
If you see black mould repeatedly, it’s often an environmental issue, not a technique issue — check your grow room, not just your process.
Can be harmful to inhale — handle carefully.
5. Blue-Green Mould (Penicillium)

Often confused with Trichoderma.
Identification:
Common In:
Why It Happens:
Prevention:
Expert Tip:
Penicillium appears more blue and dusty earlier than Trichoderma — spotting this early can save nearby cultures.
6. Lipstick Mould (Neurospora)

Identification:
Common In:
Why It Happens:
Prevention:
Expert Tip:
Lipstick mould spreads extremely fast — if you see even a small patch, assume the entire batch is compromised.
7. Yeast Mould

Identification:
Common In:
Why It Happens:
Prevention:
Expert Tip:
Yeast often goes unnoticed because it’s not fuzzy — if growth looks “wet” or creamy instead of fibrous, suspect yeast..
8. Pink Mould (Fusarium)

Identification:
Common In:
Why It Happens:
Prevention:
Expert Tip:
Fusarium can linger in your grow space — recurring outbreaks usually mean your environment needs deep cleaning, not just better technique.
9. Wet Bubble Disease (Mycogone)

Identification:
Common In:
Why It Happens:
Prevention:
Expert Tip:
Unlike most contaminants, Mycogone deforms mushrooms instead of just competing with mycelium — if your fruits look mutated, suspect it immediately.
10. Pin Mould Contamination (Mucor)

Identification:
Common In:
Mucor spores are everywhere in the environment [3], making it one of the most frequent contaminants in:
Why It Happens:
Prevention:
Expert Tip:
Pin mould often tricks growers early on — if growth suddenly “reaches upward” instead of spreading outward, it’s not mycelium.
Contamination by Grow Stage
Agar Plate Contamination
Usually caused by poor sterile technique.
Grain Spawn Contamination
Most common failure point for beginners.
Bulk Substrate Contamination
Often caused by airflow and humidity imbalance.
Preventing Mushroom Contamination

1. Master Sterile Technique
2. Perfect Your Sterilisation

3. Control Moisture Levels
4. Improve Airflow & Filtration
5. Reduce Exposure
Advanced Grower Insights
From practical cultivation experience:
Conclusion

Mushroom contamination isn’t random — it’s predictable, identifiable, and preventable.
By understanding the 10 most common mushroom contaminations, learning how to identify contaminated mycelium, and applying strict sterilsation techniques, you dramatically increase your success rate.
If you remember one thing:
Clean technique + early detection = more contamination-free grows.
Master that, and your yields will follow.
Identifying Contamination .. there’s an Easier Way

Even with perfect sterile technique, contamination can still happen. Airborne spores, hidden bacteria, and tiny mistakes during inoculation are often enough to ruin an entire batch. That’s exactly why many growers — especially beginners — hit a wall. You can follow every rule… and still lose jars. Identifying contamination is pivotal to knowing how to prevent it.
Introducing the Contam Buster (Your Contamination Safety Net)
If you’re tired of guessing whether your process is clean enough, the Contam Buster was designed to remove that uncertainty with the power of AI.
It helps to:
- Reduce contamination risk during inoculation.
- Create a cleaner working environment instantly.
- Improve success rates with agar, grain spawn, and bulk substrate.
- Grow with confidence — even as a beginner.
Why Accurate Identification Matters
Most contamination doesn’t come from obvious mistakes — it comes from invisible exposure:
What will the Contam Buster tell me?
Our AI powered Contam Buster will give you:
- A diagnosis of most probable contamination (or healthy mycelium).
- A level of confidence in the diagnosis.
- Visual Indicators.
- Probable Causes.
- Recommended Action.
- Prevention Strategy (for next time).
- Other possibilities considered.

The Contam Buster tackles the root problem: your environment.
Who is the Contam Buster for?
The Contam Buster is ideal if you:
Stop Losing Batches
Every contaminated grow costs you:
Instead of constantly troubleshooting, you can focus on what actually matters — healthy, aggressive mycelium and consistent harvests.
Check out Contam Buster.
Frequently Asked Questions
Contaminated mycelium often shows unusual colours like green, black, pink, or orange instead of bright white. It may appear slimy, patchy, or produce a sour smell. Healthy mycelium is consistently white, thick, and fast-growing. For a second opinion check out our free to use AI Contam Buster.
Trichoderma (green mould) is the most common contamination. It spreads rapidly and thrives in poorly sterilised substrates, often overtaking grain spawn and bulk substrate within days.
You prevent contamination by using sterile technique, properly sterilising substrates, controlling moisture levels, and minimising exposure to airborne spores during inoculation and colonisation stages.
Grain spawn contamination is usually caused by excess moisture, incomplete sterilisation, or poor inoculation practices. Ensuring correct hydration and pressure cooking at 15 PSI significantly reduces contamination risk.
In most cases, contaminated grows cannot be saved. Removing them quickly is essential to prevent spores from spreading and infecting other mushroom cultures.
- WikiPedia — Trichoderma. Available at: https://en.wikipedia.org/wiki/Trichoderma#Causal_agent_of_disease (Accessed 3 April 2026).
- Dr Fungus — Aspergillus Species. Available at: https://drfungus.org/knowledge-base/aspergillus-species/ (Accessed 12 April 2026).
- WikiMedia Volume 35, Issue 6 (2023) — Mucor. Available at: https://species.wikimedia.org/wiki/Mucor (Accessed 3 April 2026).
- International Journal of Plant & Soil Science (2022) — Fungal and Bacterial Contaminants Associated with the Spoilage of Mushroom Spawn. Available at: https://journalijpss.com/index.php/IJPSS/article/download/2842/5668/5177?__cf_chl_tk=HC9YEfLiCstzsPm83NKGBwS5ZuVke40swTP_G48EyPw-1777392753-1.0.1.1-WDOsRZ2h1OUa4pDjsR2flwgH5cClUAbVnb_1WSqo1jE (Accessed 11 April 2025).




